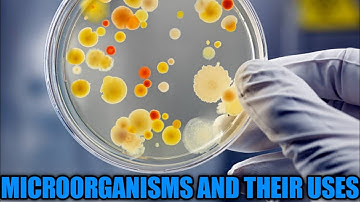
Microorganisms Class 8 CBSE|  सूक्ष्म जीव । Microorganisms| Microbes| Microorganisms uses

⬇ DOWNLOAD NOW
Kalau muncul iklan pop-up, tutup lalu klik tombol kembali
Download lagu सूक्ष्मजीव: सूक्ष्मजीवों के प्रकार। micro-organisms |types of micro organisms|class 8 science|JCERT secara gratis hanya untuk keperluan promosi. Dukung artis favorit kamu dengan membeli musik original di iTunes atau platform resmi lainnya.
 Chart on Different types of Micro organisms
Chart on Different types of Micro organisms
Microorganisms Class 8 CBSE| सूक्ष्म जीव । Microorganisms| Microbes| Microorganisms uses
Microorganisms Class 8 CBSE| सूक्ष्म जीव । Microorganisms| Microbes| Microorganisms uses
 Microorganisms (सूक्ष्मजीव) | Bacteria,fungi,algae,virus,protozoa | class 8th science | cbse
Microorganisms (सूक्ष्मजीव) | Bacteria,fungi,algae,virus,protozoa | class 8th science | cbse
 सूक्ष्मजीव - मित्र एवं शत्रु १/२ (Microorganisms - Friend and Foe 1/2) - Class 8 Science - Hindi
सूक्ष्मजीव - मित्र एवं शत्रु १/२ (Microorganisms - Friend and Foe 1/2) - Class 8 Science - Hindi
 CLASS 8 SCIENCE CHAPTER 8 | WORLD OF MICROORGANISM -1 | सूक्ष्मजीवों का संसार -1
CLASS 8 SCIENCE CHAPTER 8 | WORLD OF MICROORGANISM -1 | सूक्ष्मजीवों का संसार -1
 #1 Class 8: Microorganisms (Types of microorganisms).
#1 Class 8: Microorganisms (Types of microorganisms).